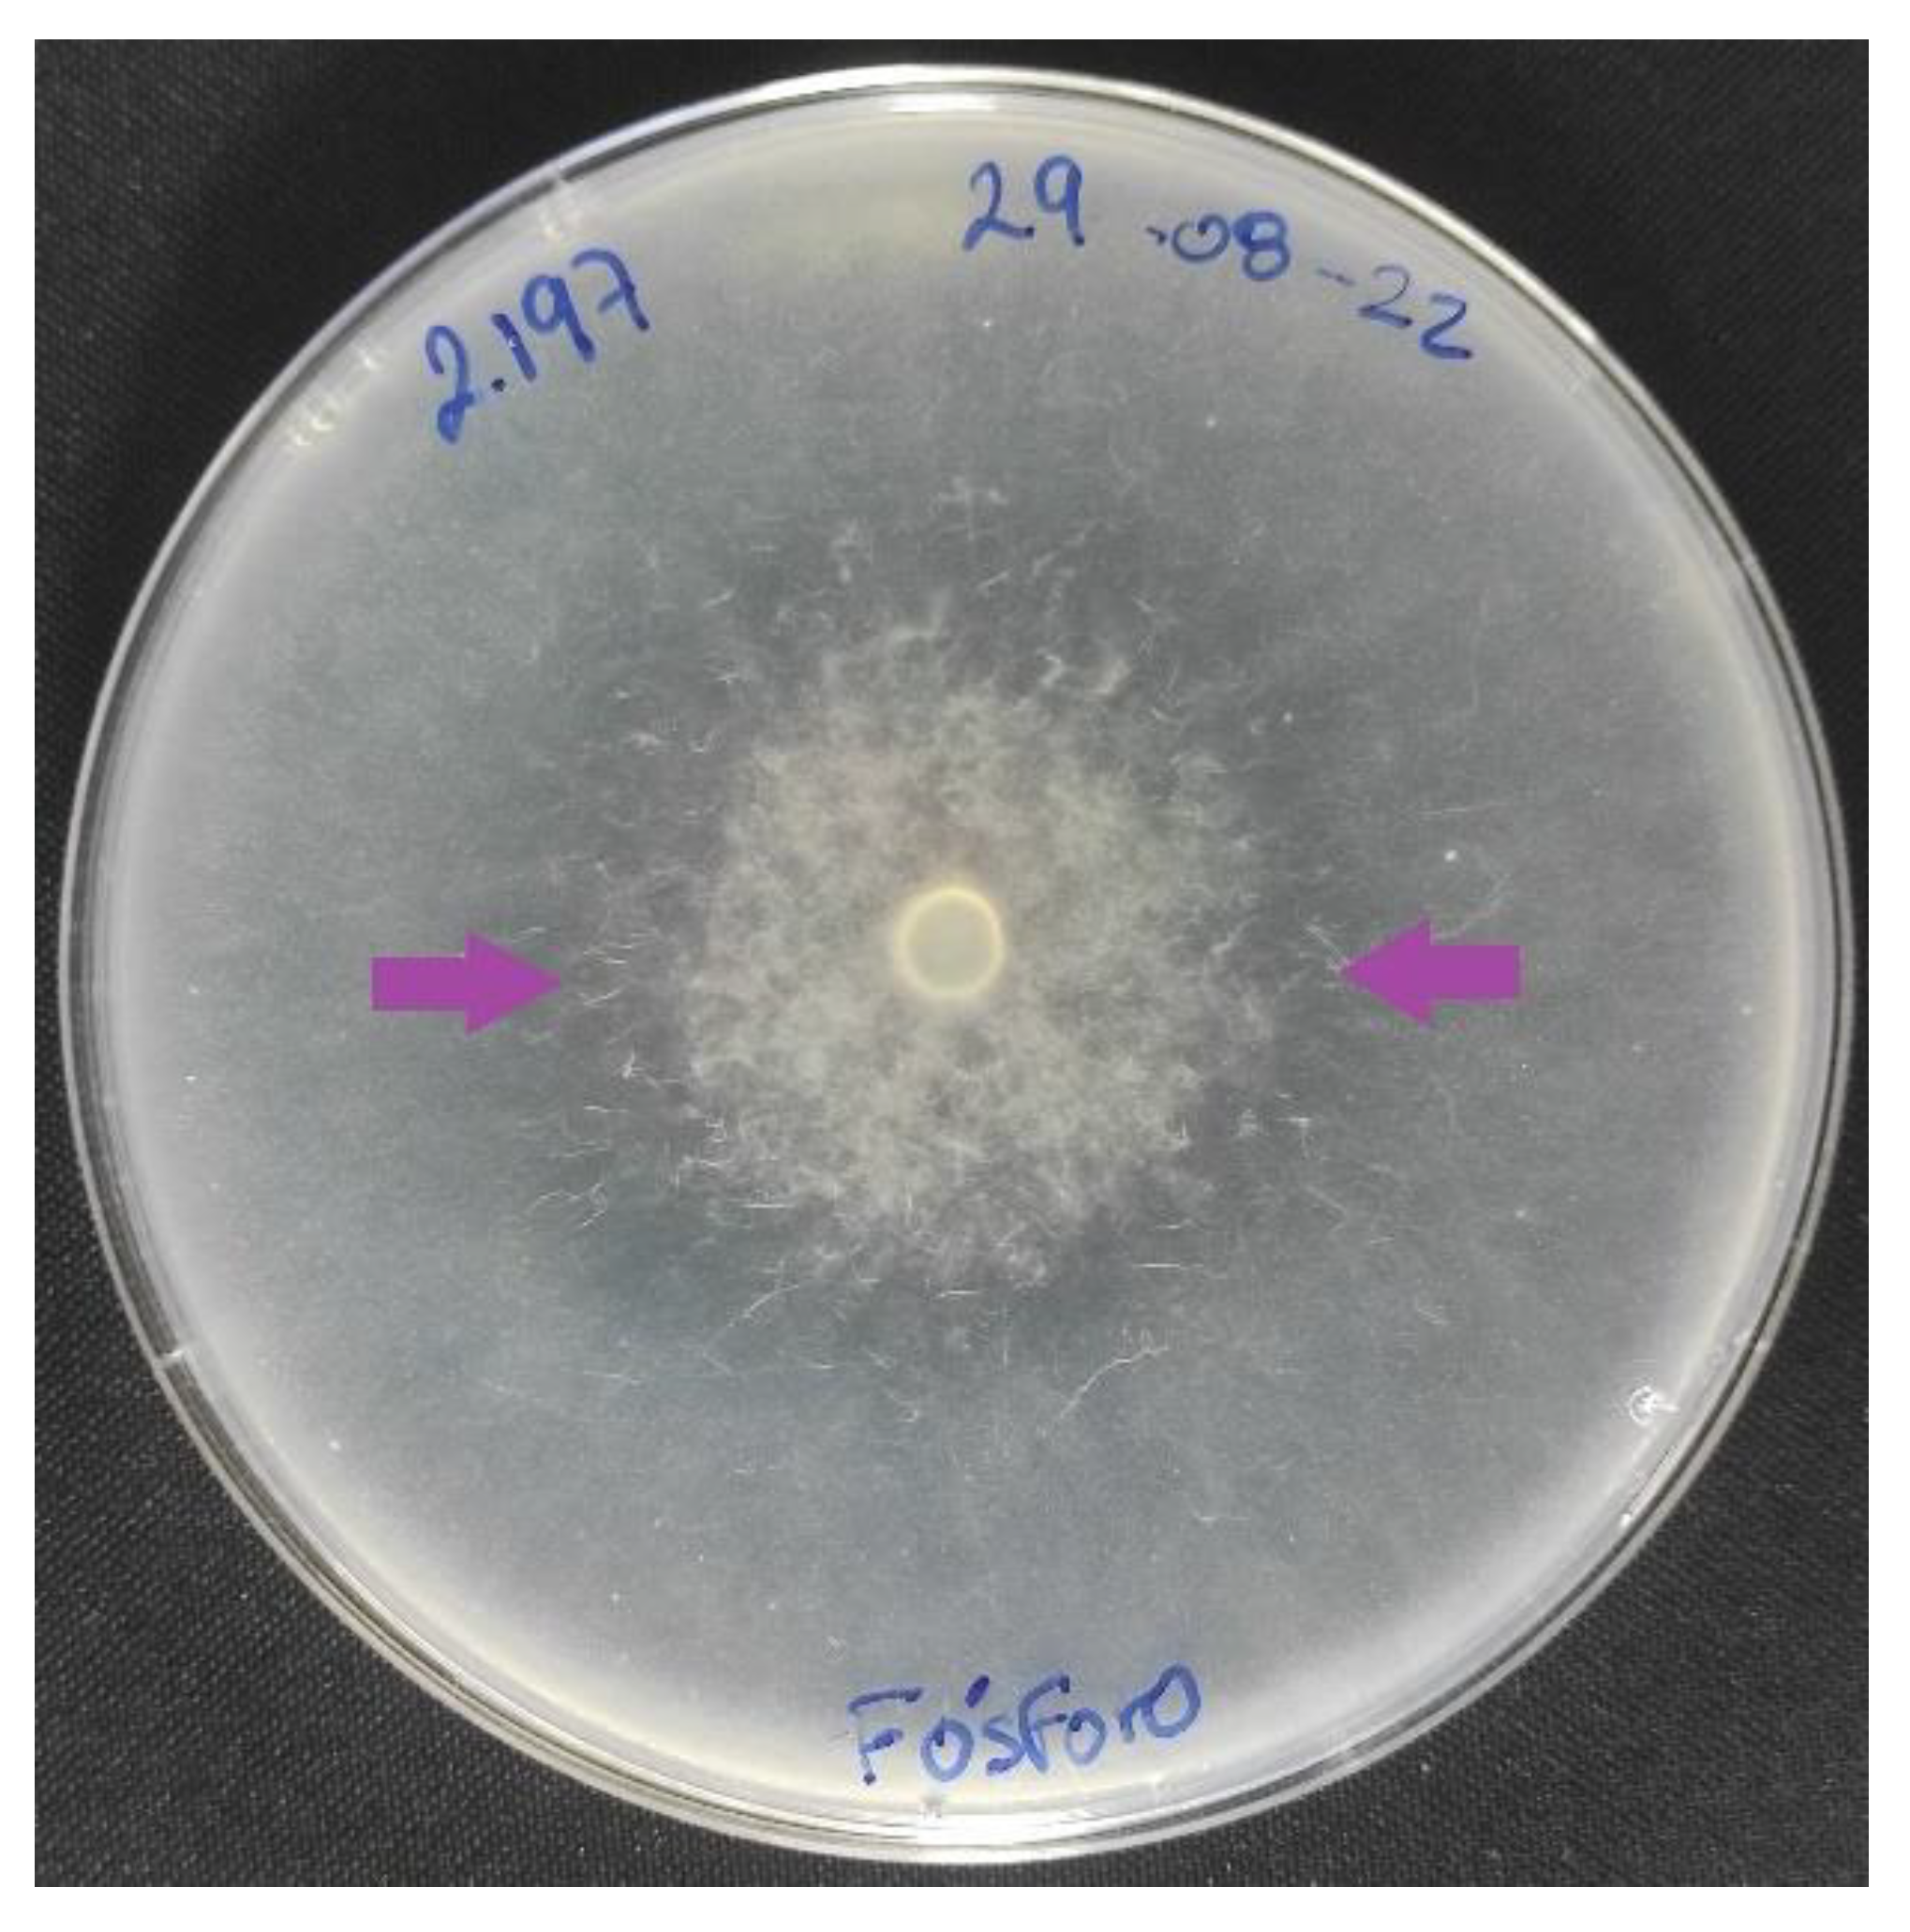
Microorganisms 11 00137 g002 Microorganisms 11 00137 g002

Nematophagous Fungi: A Review of Their Phosphorus Solubilization Potential
Abstract
1. Introduction
2. Mechanisms of P solubilization by NF
2.1. Organic Acids
2.2. Solubilizing Enzymes
2.3. Siderophore Production
3. Potential of NF in P Solubilization
4. Trapping Nematodes—Predatory Fungi
5. Endoparasitic and Egg-parasitic Fungi
6. Toxin Production
7. Filamentous Fungi with Nematophagous Activity
| Type of Fungi | Fungi | Structure Involved | Substance That Is Solubilized | Solubilization Mechanism | Reference |
|---|---|---|---|---|---|
| Predatory | Arthrobotrys oligospora | Adhesive networks | Phosphate rock | pH of the culture medium. | [58] |
| Arthrobotrys conoides and Duddingtonia flagrans | Adhesive networks Adhesive networks | Tricalcium, zinc, and aluminum phosphate phosphate rock | pH of the culture medium. Production of organic acids | [56] | |
| Duddingtonia flagrans | Adhesive networks | Phosphorus | - | [2,3] | |
| Nematode egg-parasitic | Pochonia chlamydosporia | Appressoria and hyphae | Phosphorus | Phosphatases and organic acids | [3,62,63] |
| Purpureocillium variotii | Toxic metabolites | Phosphorus | Siderophores and pH of the culture medium | [68] | |
| Purpureocillium hepiali | Toxic metabolites | Phosphate | pH of the culture medium | [67] | |
| Purpureocillium lilacinum | Toxic metabolites | Calcium and iron phosphate | pH of the culture medium and organic acids | [83] | |
| Toxin producing | Piriformospora indica | Metabolites | Organic and inorganic phosphorus | pH of the culture medium | [73,75,84] |
| Pleurotus ostreatus | Toxins | Phosphate rock | Organic acids: tartaric, malic, citric, lactic, succinic and four unknown acids | [71,85] | |
| Filamentous fungi with indetermined nematophagous mechanism | Trichoderma harzianum | Hydrolytic enzymes | Calcium phosphate | pH of the culture medium, production of chelating metabolites, and redox activity | [26] |
| Trichoderma asperellum | Hydrolytic enzymes | Monopotassium phosphate Phytate Phosphate rock | pH of the culture medium and organic anions | [86] | |
| Trichoderma spp. | Hydrolytic enzymes | Phosphate | Organic acids | [87] | |
| Aspergillus niger, Penicillium canescens, Eupenicillium ludwigii, and Penicillium islandicum | Hydrolytic enzymes | Phosphate rock | pH of the culture medium, acids: oxalic, citric, and gluconic | [31] | |
| Aspergillus, Penicillium, Trichoderma, Fusarium, Mucor, Ovularopsis, Tritirachium, and Geotrichum | Hydrolytic enzymes | Phosphate rock Tricalcium phosphate | Acids: fumaric, acetic, gluconic, lactic, and succinic | [29] | |
| Penicillium expansum, Mucor ramosissimus, and Candida krissii | Hydrolytic enzymes | Phosphate rock | Acids: citric, oxalic, and gluconic | [79] | |
| Penicillium guanacastense | Hydrolytic enzymes | Organic and inorganic phosphorus | Acids: gluconic, oxalic, lactic, and malonic | [32] | |
| Penicillium bilaji and Penicillium cf.fuscum | Hydrolytic enzymes | Phosphate rock | Organic acids | [30] | |
| Aspergillus niger | Hydrolytic enzymes | Various forms of soluble P calcium iron aluminum phosphate | Acids: gluconic, oxalic, tartaric | [14,33] | |
| Aspergillus aculeatus | Hydrolytic enzymes | Phosphate rock | pH of the culture medium | [88] | |
| Rhizopus stolonifer, Aspergillus niger, and Alternaria alternata | Hydrolytic enzymes | Calcium phosphate | Organic acids | [89] | |
| Aspergillus tubingensis | Hydrolytic enzymes | Phosphate rock | pH of the culture medium | [90] | |
| Penicillium oxalicum and Aspergillus niger | Hydrolytic enzymes | Tricalcium phosphate | Organic acids | [91] | |
| Penicillium bilaii | Hydrolytic enzymes | Calcium phosphate | Acids: citric and oxalic | [92] | |
| Aspergillus niger and Penicillium italicum | Hydrolytic enzymes | Tricalcium phosphate | pH of the culture medium | [93] | |
| Penicillium oxalicum, Trichoderma virens, and Aspergillus | Hydrolytic enzymes | Insoluble tricalcium phosphate, soluble dipotassium hydrogen phosphate | pH of the culture medium and organic acids | [94] | |
| Penicillium | Hydrolytic enzymes | Phosphate | pH of the culture medium | [95] | |
| Penicillium oxalicum | Hydrolytic enzymes | Phosphate | Organic acids | [96] | |
| Paecilomyces, Trichoderma, Aspergillus, Fusarium, and Gongronella | Hydrolytic enzymes | Calcium phosphate Iron phosphate | [78] |
8. Agricultural Solutions: Application of NF in P Solubilization
| P-Solubilizing Species | Crop | Plant Benefits | Reference |
|---|---|---|---|
| Geomyces pannorum, Paecilomyces carneus | Avena sativa | Increase availability of phosphorus in the soil and mitigate phytoparasitic nematodes | [106] |
| Duddingtonia flagrans Pochonia chlamydosporia | Soy bean and tomato | Reductions in the number of eggs and galls per gram of root and increased nutrient content in roots | [2,3] |
| Pochonia chlamydosporia | Tomato | Increase in secondary roots and increase in the total weight root of seedlings Reduction in flowering and fruiting times and greater weight of mature fruits | [62] |
| P. chlamydosporia | Maize Cowpea | Promoting root growth | [107] |
| Purpureocillium lilacinum Purpureocillium lavendulum Metarhizium marquandii | Maize Beans Soy bean | Plant growth promotion and availability of P and N | [104] |
| Purpureocillium lilacinum | Tomato | Plant growth promotion and phosphorus solubilization | [69] |
| Pleurotus ostreatus | Maize | Increase in root and shoot lengths, fresh and dry root weights, fresh and dry shoot weights, chlorophyll content, and nutrient uptake | [71] |
| Trichoderma, Purpureocillium | Banana | Active production of indole-3-acetic acid IAA and solubilize insoluble phosphate | [99] |
| Trichoderma | Soy bean | Plant growth promotion increase of P uptake efficiency | [82,87] |
| Aspergillus niger, A. fumigatus, Penicillium pinophilum | Wheat and faba bean | Yield of wheat grains and faba bean seed production | [108] |
| Penicillium oxalicum | Wheat and maize | Replace chemical fertilizer in alkaline soils. Improved crop production | [101] |
| Penicillium sp. Penicillium oxalicum | Maize | Increased uptake of P by plants and increased availability of P in soil | [100] |
| Penicillium sp. Aspergillus foetidus | Sorghum bicolor L. | P uptake and increased growth | [109] |
| Penicillium expansum, Mucor ramosissimus, Candida krissii | Wheat | Plant growth promotion, P available in soil, and P absorption | [79] |
| Penicillium oxalicum | Rapeseed | Solubilize inorganic P and mineralize organic P | [110] |
| Mortierella capitata | Maize | Increased biomass, chlorophyll, and gibberellic acid | [111] |
| Mortierella sp. | Avocado | Plant growth promotion and P uptake | [112] |
9. Future Research Perspectives
10. Conclusions
Author Contributions
Funding
Institutional Review Board Statement
Informed Consent Statement
Data Availability Statement
Acknowledgments
Conflicts of Interest
References
- Hallama, M.; Pekrun, C.; Lambers, H.; Kandeler, E. Hidden Miners—The Roles of Cover Crops and Soil Microorganisms in Phosphorus Cycling through Agroecosystems. Plant Soil 2019, 434, 7–45. [Google Scholar] [CrossRef]
- Balbino, H.M.; Monteiro, T.S.A.; Coutinho, R.R.; Pacheco, P.V.M.; de Freitas, L.G. Association of Duddingtonia flagrans with Microorganisms for Management of Meloidogyne javanica and Acquisition of Nutrients in Soybean. Biol. Control 2021, 159, 104626. [Google Scholar] [CrossRef]
- Monteiro, T.S.A.; Valadares, S.V.; de Mello, I.N.K.; Moreira, B.C.; Kasuya, M.C.M.; de Araújo, J.V.; de Freitas, L.G. Nematophagus Fungi Increasing Phosphorus Uptake and Promoting Plant Growth. Biol. Control 2018, 123, 71–75. [Google Scholar] [CrossRef]
- Kumar, A.; Kumar, A.; Patel, H. Role of Microbes in Phosphorus Availability and Acquisition by Plants. Int. J. Curr. Microbiol. Appl. Sci. 2018, 7, 1344–1347. [Google Scholar] [CrossRef]
- Maharana, R.; Singh, B.S.M.; Mandal, K.; Dhal, N.K. Microbial-Mediated Mechanism to Improve Rock Phosphate Solubilization and Its Agronomic Implications. In Enzymes for Pollutant Degradation; Mulla, S.I., Bharagava, R.N., Eds.; Microorganisms for Sustainability; Springer Nature: Singapore, 2022; pp. 327–339. ISBN 9789811645747. [Google Scholar]
- El Maaloum, S.; Elabed, A.; Alaoui-Talibi, Z.E.; Meddich, A.; Filali-Maltouf, A.; Douira, A.; Ibnsouda-Koraichi, S.; Amir, S.; El Modafar, C. Effect of Arbuscular Mycorrhizal Fungi and Phosphate-Solubilizing Bacteria Consortia Associated with Phospho-Compost on Phosphorus Solubilization and Growth of Tomato Seedlings (Solanum lycopersicum L.). Commun. Soil Sci. Plant Anal. 2020, 51, 622–634. [Google Scholar] [CrossRef]
- Tian, J.; Ge, F.; Zhang, D.; Deng, S.; Liu, X. Roles of Phosphate Solubilizing Microorganisms from Managing Soil Phosphorus Deficiency to Mediating Biogeochemical P Cycle. Biology 2021, 10, 158. [Google Scholar] [CrossRef]
- Kalayu, G. Phosphate Solubilizing Microorganisms: Promising Approach as Biofertilizers. Int. J. Agron. 2019, 2019, e4917256. [Google Scholar] [CrossRef]
- Raymond, N.S.; Gómez-Muñoz, B.; van der Bom, F.J.T.; Nybroe, O.; Jensen, L.S.; Müller-Stöver, D.S.; Oberson, A.; Richardson, A.E. Phosphate-Solubilising Microorganisms for Improved Crop Productivity: A Critical Assessment. New Phytol. 2021, 229, 1268–1277. [Google Scholar] [CrossRef]
- Marra, L.M.; de Oliveira-Longatti, S.M.; Soares, C.R.F.S.; Olivares, F.L.; Moreira, F.M.d.S. The Amount of Phosphate Solubilization Depends on the Strain, C-Source, Organic Acids and Type of Phosphate. Geomicrobiol. J. 2019, 36, 232–242. [Google Scholar] [CrossRef]
- Billah, M.; Khan, M.; Bano, A.; Hassan, T.U.; Munir, A.; Gurmani, A.R. Phosphorus and Phosphate Solubilizing Bacteria: Keys for Sustainable Agriculture. Geomicrobiol. J. 2019, 36, 904–916. [Google Scholar] [CrossRef]
- Kour, D.; Rana, K.L.; Kaur, T.; Yadav, N.; Yadav, A.N.; Kumar, M.; Kumar, V.; Dhaliwal, H.S.; Saxena, A.K. Biodiversity, Current Developments and Potential Biotechnological Applications of Phosphorus-Solubilizing and -Mobilizing Microbes: A Review. Pedosphere 2021, 31, 43–75. [Google Scholar] [CrossRef]
- Puente, M.E.; Bashan, Y.; Li, C.Y.; Lebsky, V.K. Microbial Populations and Activities in the Rhizoplane of Rock-Weathering Desert Plants. I. Root Colonization and Weathering of Igneous Rocks. Plant Biol. 2004, 6, 629–642. [Google Scholar] [CrossRef] [PubMed]
- Chuang, C.-C.; Kuo, Y.-L.; Chao, C.-C.; Chao, W.-L. Solubilization of Inorganic Phosphates and Plant Growth Promotion by Aspergillus niger. Biol. Fertil. Soils 2007, 43, 575–584. [Google Scholar] [CrossRef]
- Zhang, Y.; Chen, F.-S.; Wu, X.-Q.; Luan, F.-G.; Zhang, L.-P.; Fang, X.-M.; Wan, S.-Z.; Hu, X.-F.; Ye, J.-R. Isolation and characterization of two phosphate-solubilizing fungi from rhizosphere soil of moso bamboo and their functional capacities when exposed to different phosphorus sources and pH environments. PLoS ONE 2018, 13, e0199625. [Google Scholar] [CrossRef] [PubMed]
- Rawat, P.; Das, S.; Shankhdhar, D.; Shankhdhar, S.C. Phosphate-Solubilizing Microorganisms: Mechanism and Their Role in Phosphate Solubilization and Uptake. J. Soil Sci. Plant Nutr. 2021, 21, 49–68. [Google Scholar] [CrossRef]
- Sun, H.; Wu, Y.; Zhou, J.; Yu, D.; Chen, Y. Microorganisms Drive Stabilization and Accumulation of Organic Phosphorus: An Incubation Experiment. Soil Biol. Biochem. 2022, 172, 108750. [Google Scholar] [CrossRef]
- Quevedo, A.; Magdama, F.; Castro, J.; Vera-Morales, M. Interacciones ecológicas de los hongos nematófagos y su potencial uso en cultivos tropicales. Sci. Agropecu. 2022, 13, 97–108. [Google Scholar] [CrossRef]
- Soares, F.E.d.F.; Gôlo, P.S.; Fernandes, É.K.K. Chapter 23—Nematophagous and Entomopathogenic Fungi: New Insights into the Beneficial Fungus-Plant Interaction. In Molecular Aspects of Plant Beneficial Microbes in Agriculture; Sharma, V., Salwan, R., Al-Ani, L.K.T., Eds.; Academic Press: Cambridge, MA, USA, 2020; pp. 295–304. ISBN 978-0-12-818469-1. [Google Scholar]
- Alori, E.T.; Glick, B.R.; Babalola, O.O. Microbial Phosphorus Solubilization and Its Potential for Use in Sustainable Agriculture. Front. Microbiol. 2017, 8, 971. [Google Scholar] [CrossRef]
- Bargaz, A.; Lyamlouli, K.; Chtouki, M.; Zeroual, Y.; Dhiba, D. Soil Microbial Resources for Improving Fertilizers Efficiency in an Integrated Plant Nutrient Management System. Front. Microbiol. 2018, 9, 1606. [Google Scholar] [CrossRef]
- Wang, Y.; Lambers, H. Root-Released Organic Anions in Response to Low Phosphorus Availability: Recent Progress, Challenges and Future Perspectives. Plant Soil 2020, 447, 135–156. [Google Scholar] [CrossRef]
- Syers, J.K.; Johnston, A.E.; Curtin, D. Efficiency of Soil and Fertilizer Phosphorus Use. Reconciling Changing Concepts of Soil Phosphorus Behaviour with Agronomic Information; FAO Fertilizer and Plant Nutrition Bulletin: Rome, Italy, 2008. [Google Scholar]
- Alaylar, B.; Egamberdieva, D.; Gulluce, M.; Karadayi, M.; Arora, N.K. Integration of Molecular Tools in Microbial Phosphate Solubilization Research in Agriculture Perspective. World J. Microbiol. Biotechnol. 2020, 36, 93. [Google Scholar] [CrossRef] [PubMed]
- Thakur, D.; Kaushal, R.; Shyam, V. Phosphate Solubilising Microorganisms: Role in Phosphorus Nutrition of Crop Plants- a Review. Agric. Rev. 2014, 35, 159–171. [Google Scholar] [CrossRef]
- Altomare, C.; Norvell, W.; Björkman, T.; Harman, G. Solubilization of Phosphates and Micronutrients by the Plant-Growth-Promoting and Biocontrol Fungus Trichoderma harzianum Rifai 1295-22. Appl. Environ. Microbiol. 1999, 65, 2926–2933. [Google Scholar] [CrossRef] [PubMed]
- Yang, X.; Kong, Y.; Guo, E.; Chen, X.; Li, L. ·Organic Acid Regulation of Inorganic Phosphorus Release from Mollisols with Different Organic Matter Contents. Soil Use Manag. 2022, 38, 576–583. [Google Scholar] [CrossRef]
- Magnuson, J.K.; Lasure, L.L. Organic Acid Production by Filamentous Fungi. In Advances in Fungal Biotechnology for Industry, Agriculture, and Medicine; Tkacz, J.S., Lange, L., Eds.; Springer: Boston, MA, USA, 2004; pp. 307–340. ISBN 978-1-4419-8859-1. [Google Scholar]
- Akintokun, A.K.; Akande, G.A.; Akintokun, P.O.; Popoola, T.O.S.; Babalola, A.O. Solubilization of Insoluble Phosphate by Organic Acid-Producing Fungi Isolated from Nigerian Soil. Int. J. Soil Sci. 2007, 2, 301–307. [Google Scholar] [CrossRef][Green Version]
- Asea, P.E.A.; Kucey, R.M.N.; Stewart, J.W.B. Inorganic Phosphate Solubilization by Two Penicillium Species in Solution Culture and Soil. Soil Biol. Biochem. 1988, 20, 459–464. [Google Scholar] [CrossRef]
- De Oliveira, G.; Moreira de Freitas, A.L.; Liparini Pereira, O.; Ribeiro da Silva, I.; Bojkov Vassilev, N.; Dutra Costa, M. Mechanisms of Phosphate Solubilization by Fungal Isolates When Exposed to Different P Sources. Ann. Microbiol. 2014, 64, 239–249. [Google Scholar] [CrossRef]
- Qiao, H.; Sun, X.-R.; Wu, X.-Q.; Li, G.-E.; Wang, Z.; Li, D.-W. The Phosphate-Solubilizing Ability of Penicillium guanacastense and Its Effects on the Growth of Pinus massoniana in Phosphate-Limiting Conditions. Biol. Open 2019, 8, bio046797. [Google Scholar] [CrossRef]
- Li, X.; Luo, L.; Yang, J.; Li, B.; Yuan, H. Mechanisms for Solubilization of Various Insoluble Phosphates and Activation of Immobilized Phosphates in Different Soils by an Efficient and Salinity-Tolerant Aspergillus niger Strain An2. Appl. Biochem. Biotechnol. 2015, 175, 2755–2768. [Google Scholar] [CrossRef]
- Tian, D.; Wang, L.; Hu, J.; Zhang, L.; Zhou, N.; Xia, J.; Xu, M.; Yusef, K.K.; Wang, S.; Li, Z.; et al. A Study of P Release from Fe-P and Ca-P via the Organic Acids Secreted by Aspergillus niger. J. Microbiol. 2021, 59, 819–826. [Google Scholar] [CrossRef]
- Zhang, K.; Zhang, B.; Yang, S.-T. Production of Citric, Itaconic, Fumaric, and Malic Acids in Filamentous Fungal Fermentations. In Bioprocessing Technologies in Biorefinery for Sustainable Production of Fuels, Chemicals, and Polymers; John Wiley & Sons, Ltd.: Hoboken, NJ, USA, 2013; pp. 375–398. ISBN 978-1-118-64204-7. [Google Scholar]
- Sadaf, N.; Haider, M.Z.; Iqbal, N.; Abualreesh, M.H.; Alatawi, A. Harnessing the Phytase Production Potential of Soil-Borne Fungi from Wastewater Irrigated Fields Based on Eco-Cultural Optimization under Shake Flask Method. Agriculture 2022, 12, 103. [Google Scholar] [CrossRef]
- Azeem, M.; Riaz, A.; Chaudhary, A.N.; Hayat, R.; Hussain, Q.; Tahir, M.I.; Imran, M. Microbial Phytase Activity and Their Role in Organic P Mineralization. Arch. Agron. Soil Sci. 2015, 61, 751–766. [Google Scholar] [CrossRef]
- Kaur, P.; Vohra, A.; Satyanarayana, T. Multifarious Applications of Fungal Phytases. In Encyclopedia of Mycology; Zaragoza, Ó., Casadevall, A., Eds.; Elsevier: Oxford, UK, 2021; pp. 358–369. ISBN 978-0-323-85180-0. [Google Scholar]
- Hou, X.; Shen, Z.; Li, N.; Kong, X.; Sheng, K.; Wang, J.; Wang, Y. A Novel Fungal Beta-Propeller Phytase from Nematophagous Arthrobotrys oligospora: Characterization and Potential Application in Phosphorus and Mineral Release for Feed Processing. Microb. Cell Factories 2020, 19, 84. [Google Scholar] [CrossRef] [PubMed]
- Hider, R.C.; Kong, X. Chemistry and Biology of Siderophores. Nat. Prod. Rep. 2010, 27, 637–657. [Google Scholar] [CrossRef] [PubMed]
- Oberegger, H.; Schoeser, M.; Zadra, I.; Abt, B.; Haas, H. SREA Is Involved in Regulation of Siderophore Biosynthesis, Utilization and Uptake in Aspergillus nidulans. Mol. Microbiol. 2001, 41, 1077–1089. [Google Scholar] [CrossRef]
- Schrettl, M.; Ibrahim-Granet, O.; Droin, S.; Huerre, M.; Latgé, J.-P.; Haas, H. The Crucial Role of the Aspergillus fumigatus Siderophore System in Interaction with Alveolar Macrophages. Microbes Infect. 2010, 12, 1035–1041. [Google Scholar] [CrossRef]
- Tamariz-Angeles, C.; Huamán, G.D.; Palacios-Robles, E.; Olivera-Gonzales, P.; Castañeda-Barreto, A. Characterization of Siderophore-Producing Microorganisms Associated to Plants from High-Andean Heavy Metal Polluted Soil from Callejón de Huaylas (Ancash, Perú). Microbiol. Res. 2021, 250, 126811. [Google Scholar] [CrossRef]
- Ghosh, S.K.; Bera, T.; Chakrabarty, A.M. Microbial Siderophore—A Boon to Agricultural Sciences. Biol. Control 2020, 144, 104214. [Google Scholar] [CrossRef]
- Al-Ani, L.K.T.; Soares, F.E.d.F.; Sharma, A.; de los Santos-Villalobos, S.; Valdivia-Padilla, A.V.; Aguilar-Marcelino, L. Strategy of Nematophagous Fungi in Determining the Activity of Plant Parasitic Nematodes and Their Prospective Role in Sustainable Agriculture. Front. Fungal Biol. 2022, 3, 863198. [Google Scholar] [CrossRef]
- López-Llorca, L.V.; Maciá-Vicente, J.G.; Jansson, H.-B. Mode of Action and Interactions of Nematophagous Fungi. In Integrated Management and Biocontrol of Vegetable and Grain Crops Nematodes; Ciancio, A., Mukerji, K.G., Eds.; Springer: Dordrecht, The Netherlands, 2008; pp. 51–76. ISBN 978-1-4020-6063-2. [Google Scholar]
- Vera-Morales, M.; Castañeda-Ruiz, R.F.; Sosa, D.; Quevedo, A.; Naranjo-Morán, J.; Serrano, L.; Ratti, M.F. Mecanismos de captura, colonización y alimentación empleados por parásitos y predadores de nematodos. Ecosistemas 2022, 31, 2390. [Google Scholar] [CrossRef]
- Zhang, Y.; Li, S.; Li, H.; Wang, R.; Zhang, K.-Q.; Xu, J. Fungi–Nematode Interactions: Diversity, Ecology, and Biocontrol Prospects in Agriculture. J. Fungi 2020, 6, 206. [Google Scholar] [CrossRef] [PubMed]
- Islam, W.; Adnan, M.; Shabbir, A.; Naveed, H.; Abubakar, Y.S.; Qasim, M.; Tayyab, M.; Noman, A.; Nisar, M.S.; Khan, K.A.; et al. Insect-Fungal-Interactions: A Detailed Review on Entomopathogenic Fungi Pathogenicity to Combat Insect Pests. Microb. Pathog. 2021, 159, 105122. [Google Scholar] [CrossRef] [PubMed]
- Idrees, A.; Afzal, A.; Qadir, Z.A.; Li, J. Bioassays of Beauveria bassiana Isolates against the Fall Armyworm, Spodoptera frugiperda. J. Fungi 2022, 8, 717. [Google Scholar] [CrossRef]
- Yan, J.; Liu, H.; Idrees, A.; Chen, F.; Lu, H.; Ouyang, G.; Meng, X. First Record of Aspergillus fijiensis as an Entomopathogenic Fungus against Asian Citrus Psyllid, Diaphorina citri Kuwayama (Hemiptera: Liviidae). J. Fungi 2022, 8, 1222. [Google Scholar] [CrossRef] [PubMed]
- Idrees, A.; Qadir, Z.A.; Akutse, K.S.; Afzal, A.; Hussain, M.; Islam, W.; Waqas, M.S.; Bamisile, B.S.; Li, J. Effectiveness of Entomopathogenic Fungi on Immature Stages and Feeding Performance of Fall Armyworm, Spodoptera frugiperda (Lepidoptera: Noctuidae) Larvae. Insects 2021, 12, 1044. [Google Scholar] [CrossRef]
- França, D.V.C.; Kupper, K.C.; Magri, M.M.R.; Gomes, T.M.; Rossi, F. Trichoderma spp. Isolates with Potential of Phosphate Solubilization and Growth Promotion in Cherry Tomato1. Pesqui. Agropecuária Trop. 2017, 47, 360–368. [Google Scholar] [CrossRef]
- Joo, J.H.; Hussein, K.A. Biological Control and Plant Growth Promotion Properties of Volatile Organic Compound-Producing Antagonistic Trichoderma spp. Front. Plant Sci. 2022, 13, 897668. [Google Scholar] [CrossRef]
- Rinu, K.; Pandey, A.; Palni, L.M.S. Utilization of Psychrotolerant Phosphate Solubilizing Fungi under Low Temperature Conditions of the Mountain Ecosystem. In Microorganisms in Sustainable Agriculture and Biotechnology; Satyanarayana, T., Johri, B.N., Eds.; Springer: Dordrecht, The Netherlands, 2012; pp. 77–90. ISBN 978-94-007-2214-9. [Google Scholar]
- Pandit, R.; Kunjadia, P.; Mukhopadhyaya, P.; Kunjadia, A. Inorganic Phosphate Solubilizing Potential of Arthrobotrys conoides and Duddingtonia flagrans, a Nematode Trapping Fungi a Potential Biocontrol Agent. Int. J. Agric. Technol. 2014, 10, 559–570. [Google Scholar]
- Quevedo, A.; Vera-Morales, M.; Espinoza-Lozano, F.; Castañeda-Ruiz, R.; Sosa, D.; Magdama, F. Assessing the Predatory Activity of Arthrobotrys oligosporus Strain C-2197 as Biocontrol of the Root-Knot Nematode Meloidogyne spp. Bionatura 2021, 6, 1586–1592. [Google Scholar] [CrossRef]
- Duponnois, R.; Kisa, M.; Plenchette, C. Phosphate-Solubilizing Potential of the Nematophagous Fungus Arthrobotrys oligospora. J. Plant Nutr. Soil Sci. 2006, 169, 280–282. [Google Scholar] [CrossRef]
- Wan, J.; Dai, Z.; Zhang, K.; Li, G.; Zhao, P. Pathogenicity and Metabolites of Endoparasitic Nematophagous Fungus Drechmeria coniospora YMF1.01759 against Nematodes. Microorganisms 2021, 9, 1735. [Google Scholar] [CrossRef] [PubMed]
- Lebrigand, K.; He, L.D.; Thakur, N.; Arguel, M.-J.; Polanowska, J.; Henrissat, B.; Record, E.; Magdelenat, G.; Barbe, V.; Raffaele, S.; et al. Comparative Genomic Analysis of Drechmeria coniospora Reveals Core and Specific Genetic Requirements for Fungal Endoparasitism of Nematodes. PLoS Genet. 2016, 12, e1006017. [Google Scholar] [CrossRef] [PubMed]
- Manzanilla-López, R.H.; Esteves, I.; Finetti-Sialer, M.M.; Hirsch, P.R.; Ward, E.; Devonshire, J.; Hidalgo-Díaz, L. Pochonia chlamydosporia: Advances and Challenges to Improve Its Performance as a Biological Control Agent of Sedentary Endo-Parasitic Nematodes. J. Nematol. 2013, 45, 1–7. [Google Scholar]
- Zavala-Gonzalez, E.A.; Escudero, N.; Lopez-Moya, F.; Aranda-Martinez, A.; Exposito, A.; Ricaño-Rodríguez, J.; Naranjo-Ortiz, M.A.; Ramírez-Lepe, M.; Lopez-Llorca, L.V. Some Isolates of the Nematophagous Fungus Pochonia chlamydosporia Promote Root Growth and Reduce Flowering Time of Tomato. Ann. Appl. Biol. 2015, 166, 472–483. [Google Scholar] [CrossRef]
- Gouveia, A.D.S.; Monteiro, T.S.A.; Valadares, S.V.; Sufiate, B.L.; de Freitas, L.G.; Ramos, H.J.D.O.; de Queiroz, J.H. Understanding How Pochonia chlamydosporia Increases Phosphorus Availability. Geomicrobiol. J. 2019, 36, 747–751. [Google Scholar] [CrossRef]
- Rosso, L.c.; Colagiero, M.; Salatino, N.; Ciancio, A. Observations on the Effect of Trophic Conditions on Pochonia chlamydosporia Gene Expression. Ann. Appl. Biol. 2014, 164, 232–243. [Google Scholar] [CrossRef]
- Sellitto, V.M.; Curto, G.; Dallavalle, E.; Ciancio, A.; Colagiero, M.; Pietrantonio, L.; Bireescu, G.; Stoleru, V.; Storari, M. Effect of Pochonia chlamydosporia-Based Formulates on the Regulation of Root-Knot Nematodes and Plant Growth Response. Front. Life Sci. 2016, 9, 177–181. [Google Scholar] [CrossRef]
- Perveen, Z.; Shahzad, S. A Comparative Study of the Efficacy of Paecilomyces species against Root-Knot Nematode Meloidogyne incognita. Pak. J. Nematol. 2013, 31, 125–135. [Google Scholar]
- Rinu, K.; Pandey, A. Slow and Steady Phosphate Solubilization by a Psychrotolerant Strain of Paecilomyces hepiali (MTCC 9621). World J. Microbiol. Biotechnol. 2011, 27, 1055–1062. [Google Scholar] [CrossRef]
- Moreno-Gavíra, A.; Diánez, F.; Sánchez-Montesinos, B.; Santos, M. Paecilomyces variotii as A Plant-Growth Promoter in Horticulture. Agronomy 2020, 10, 597. [Google Scholar] [CrossRef]
- Constantin, M.; Raut, I.; Gurban, A.-M.; Doni, M.; Radu, N.; Alexandrescu, E.; Jecu, L. Exploring the Potential Applications of Paecilomyces lilacinus 112. Appl. Sci. 2022, 12, 7572. [Google Scholar] [CrossRef]
- Lee, C.-H.; Chang, H.-W.; Yang, C.-T.; Wali, N.; Shie, J.-J.; Hsueh, Y.-P. Sensory Cilia as the Achilles Heel of Nematodes When Attacked by Carnivorous Mushrooms. Proc. Natl. Acad. Sci. USA 2020, 117, 6014–6022. [Google Scholar] [CrossRef] [PubMed]
- Maharana, R.; Basu, A.; Dhal, N.K.; Adak, T. Biosolubilization of Rock Phosphate by Pleurotus ostreatus with Brewery Sludge and Its Effect on the Growth of Maize (Zea mays L.). J. Plant Nutr. 2021, 44, 395–410. [Google Scholar] [CrossRef]
- Owaid, M.N.; Abed, I.A.; Al-Saeedi, S.S.S. Applicable Properties of the Bio-Fertilizer Spent Mushroom Substrate in Organic Systems as a Byproduct from the Cultivation of Pleurotus spp. Inf. Process. Agric. 2017, 4, 78–82. [Google Scholar] [CrossRef]
- Gill, S.S.; Gill, R.; Trivedi, D.K.; Anjum, N.A.; Sharma, K.K.; Ansari, M.W.; Ansari, A.A.; Johri, A.K.; Prasad, R.; Pereira, E.; et al. Piriformospora indica: Potential and Significance in Plant Stress Tolerance. Front. Microbiol. 2016, 7, 332. [Google Scholar] [CrossRef]
- Meena, K.K.; Mesapogu, S.; Kumar, M.; Yandigeri, M.S.; Singh, G.; Saxena, A.K. Co-Inoculation of the Endophytic Fungus Piriformospora indica with the Phosphate-Solubilising Bacterium Pseudomonas striata Affects Population Dynamics and Plant Growth in Chickpea. Biol. Fertil. Soils 2010, 46, 169–174. [Google Scholar] [CrossRef]
- Kumar, M.; Yadav, V.; Kumar, H.; Sharma, R.; Singh, A.; Tuteja, N.; Johri, A.K. Piriformospora indica Enhances Plant Growth by Transferring Phosphate. Plant Signal. Behav. 2011, 6, 723–725. [Google Scholar] [CrossRef]
- Soares, F.E.d.F.; Sufiate, B.L.; de Queiroz, J.H. Nematophagous Fungi: Far beyond the Endoparasite, Predator and Ovicidal Groups. Agric. Nat. Resour. 2018, 52, 1–8. [Google Scholar] [CrossRef]
- Cairns, T.C.; Zheng, X.; Zheng, P.; Sun, J.; Meyer, V. Turning inside out: Filamentous Fungal Secretion and Its Applications in Biotechnology, Agriculture, and the Clinic. J. Fungi 2021, 7, 535. [Google Scholar] [CrossRef]
- Vera, D.F.; Pérez, H.; Valencia, H. Aislamiento de hongos solubilizadores de fosfatos de la rizósfera de Arazá (Eugenia stipitata, Myrtaceae). Acta Biológica Colomb. 2002, 7, 33–40. [Google Scholar]
- Xiao, C.; Chi, R.; He, H.; Qiu, G.; Wang, D.; Zhang, W. Isolation of Phosphate-Solubilizing Fungi from Phosphate Mines and Their Effect on Wheat Seedling Growth. Appl. Biochem. Biotechnol. 2009, 159, 330–342. [Google Scholar] [CrossRef] [PubMed]
- Alves, G.S.; Bertini, S.C.B.; Barbosa, B.B.; Pimentel, J.P.; Ribeiro Junior, V.A.; Mendes, G.d.O.; Azevedo, L.C.B. Fungal Endophytes Inoculation Improves Soil Nutrient Availability, Arbuscular Mycorrhizal Colonization and Common Bean Growth. Rhizosphere 2021, 18, 100330. [Google Scholar] [CrossRef]
- Tyśkiewicz, R.; Nowak, A.; Ozimek, E.; Jaroszuk-Ściseł, J. Trichoderma: The Current Status of its Application in Agriculture for the Biocontrol of Fungal Phytopathogens and Stimulation of Plant Growth. Int. J. Mol. Sci. 2022, 23, 2329. [Google Scholar] [CrossRef]
- Marra, R.; Lombardi, N.; d’Errico, G.; Troisi, J.; Scala, G.; Vinale, F.; Woo, S.L.; Bonanomi, G.; Lorito, M. Application of Trichoderma Strains and Metabolites Enhances Soybean Productivity and Nutrient Content. J. Agric. Food Chem. 2019, 67, 1814–1822. [Google Scholar] [CrossRef] [PubMed]
- Hernández-Leal, T.I.; Carrión, G.; Heredia, G. Solubilización in vitro de fosfatos por una cepa de Paecilomyces lilacinus (Thom) Samson. Agrociencia 2011, 45, 881–892. [Google Scholar]
- Ngwene, B.; Boukail, S.; Söllner, L.; Franken, P.; Andrade-Linares, D.R. Phosphate Utilization by the Fungal Root Endophyte Piriformospora indica. Plant Soil 2016, 405, 231–241. [Google Scholar] [CrossRef]
- Jayasinghearachchi, H.S.; Seneviratne, G. Fungal Solubilization of Rock Phosphate Is Enhanced by Forming Fungal–Rhizobial Biofilms. Soil Biol. Biochem. 2006, 38, 405–408. [Google Scholar] [CrossRef]
- García-López, A.M.; Avilés, M.; Delgado, A. Plant Uptake of Phosphorus from Sparingly Available P- Sources as Affected by Trichoderma asperellum T34. Agric. Food Sci. 2015, 24, 249–260. [Google Scholar] [CrossRef]
- Bononi, L.; Chiaramonte, J.B.; Pansa, C.C.; Moitinho, M.A.; Melo, I.S. Phosphorus-Solubilizing Trichoderma spp. from Amazon Soils Improve Soybean Plant Growth. Sci. Rep. 2020, 10, 2858. [Google Scholar] [CrossRef]
- Narsian, V.; Patel, H.H. Aspergillus aculeatus as a Rock Phosphate Solubilizer. Soil Biol. Biochem. 2000, 32, 559–565. [Google Scholar] [CrossRef]
- Ceci, A.; Pinzari, F.; Russo, F.; Maggi, O.; Persiani, A.M. Saprotrophic Soil Fungi to Improve Phosphorus Solubilisation and Release: In Vitro Abilities of Several Species. Ambio 2018, 47, 30–40. [Google Scholar] [CrossRef]
- Jamshidi, R.; Jalili, B.; Bahmanyar, M.A.; Salek-Gilani, S. Isolation and Identification of a Phosphate Solubilising Fungus from Soil of a Phosphate Mine in Chaluse, Iran. Mycology 2016, 7, 134–142. [Google Scholar] [CrossRef] [PubMed][Green Version]
- Li, Z.; Bai, T.; Dai, L.; Wang, F.; Tao, J.; Meng, S.; Hu, Y.; Wang, S.; Hu, S. A Study of Organic Acid Production in Contrasts between Two Phosphate Solubilizing Fungi: Penicillium oxalicum and Aspergillus niger. Sci. Rep. 2016, 6, 25313. [Google Scholar] [CrossRef] [PubMed]
- Cunningham, J.; Kuiack, C. Production of Citric and Oxalic Acids and Solubilization of Calcium Phosphate by Penicillium bilaii. Appl. Environ. Microbiol. 1992, 58, 1451–1458. [Google Scholar] [CrossRef] [PubMed]
- El-Azouni, I. Effect of Phosphate Solubilizing Fungi on Growth and Nutrient Uptake of Soybean (Glycine max L.) Plants. J. Appl. Sci. Res. 2008, 4, 592–598. [Google Scholar]
- Kumari, P.D.S.U.; Nanayakkara, C.M. Phosphate-Solubilizing Fungi for Efficient Soil Phosphorus Management. Sri Lanka J. Food Agric. 2017, 3, 1–9. [Google Scholar] [CrossRef][Green Version]
- Pandey, A.; Das, N.; Kumar, B.; Rinu, K.; Trivedi, P. Phosphate Solubilization by Penicillium spp. Isolated from Soil Samples of Indian Himalayan Region. World J. Microbiol. Biotechnol. 2008, 24, 97–102. [Google Scholar] [CrossRef]
- Yang, T.; Li, L.; Wang, B.; Tian, J.; Shi, F.; Zhang, S.; Wu, Z. Isolation, Mutagenesis, and Organic Acid Secretion of a Highly Efficient Phosphate-Solubilizing Fungus. Front. Microbiol. 2022, 13, 793122. [Google Scholar] [CrossRef]
- Sharma, S.B.; Sayyed, R.Z.; Trivedi, M.H.; Gobi, T.A. Phosphate Solubilizing Microbes: Sustainable Approach for Managing Phosphorus Deficiency in Agricultural Soils. SpringerPlus 2013, 2, 587. [Google Scholar] [CrossRef]
- Peiris, P.U.S.; Li, Y.; Brown, P.; Xu, C. Fungal Biocontrol against Meloidogyne spp. in Agricultural Crops: A Systematic Review and Meta-Analysis. Biol. Control 2020, 144, 104235. [Google Scholar] [CrossRef]
- Napitupulu, T.P.; Ramadhani, I.; Kanti, A.; Sudiana, I.M. Diversity, Phosphate Solubilizing, and IAA Production of Culturable Fungi Associated with Healthy and Wilt Banana. Arch. Phytopathol. Plant Prot. 2021, 54, 2306–2332. [Google Scholar] [CrossRef]
- Qarni, A.; Billah, M.; Hussain, K.; Shah, S.H.; Ahmed, W.; Alam, S.; Sheikh, A.A.; Jafri, L.; Munir, A.; Malik, K.M.; et al. Isolation and Characterization of Phosphate Solubilizing Microbes from Rock Phosphate Mines and Their Potential Effect for Sustainable Agriculture. Sustainability 2021, 13, 2151. [Google Scholar] [CrossRef]
- Singh, H.; Reddy, M.S. Effect of Inoculation with Phosphate Solubilizing Fungus on Growth and Nutrient Uptake of Wheat and Maize Plants Fertilized with Rock Phosphate in Alkaline Soils. Eur. J. Soil Biol. 2011, 47, 30–34. [Google Scholar] [CrossRef]
- Chang, C.-H.; Yang, S.-S. Thermo-Tolerant Phosphate-Solubilizing Microbes for Multi-Functional Biofertilizer Preparation. Bioresour. Technol. 2009, 100, 1648–1658. [Google Scholar] [CrossRef]
- Djuuna, I.A.F.; Prabawardani, S.; Massora, M. Population Distribution of Phosphate-Solubilizing Microorganisms in Agricultural Soil. Microbes Environ. 2022, 37, ME21041. [Google Scholar] [CrossRef]
- Baron, N.C.; Pollo, A.d.S.; Rigobelo, E.C. Purpureocillium lilacinum and Metarhizium marquandii as Plant Growth-Promoting Fungi. PeerJ 2020, 8, e9005. [Google Scholar] [CrossRef]
- Osorio, N.W.; Habte, M. Effect of a Phosphate-Solubilizing Fungus and an Arbuscular Mycorrhizal Fungus on Leucaena Seedlings in Tropical Soils with Contrasting Phosphate Sorption Capacity. Plant Soil 2015, 389, 375–385. [Google Scholar] [CrossRef]
- Lima-Rivera, D.L.; Lopez-Lima, D.; Desgarennes, D.; Velázquez-Rodríguez, A.S.; Carrion, G. Phosphate Solubilization by Fungi with Nematicidal Potential. J. Soil Sci. Plant Nutr. 2016, 16, 507–524. [Google Scholar] [CrossRef][Green Version]
- Gomezjurado, M.E.; de Abreu, L.M.; Marra, L.M.; Pfenning, L.H.; de S. Moreira, F.M. Phosphate Solubilization by Several Genera of Saprophytic Fungi and Its Influence on Corn and Cowpea Growth. J. Plant Nutr. 2015, 38, 675–686. [Google Scholar] [CrossRef]
- Abdul, O.A.; Mehana, T.A. Impact of Phosphate-Solubilizing Fungi on the Yield and Phosphorus-Uptake by Wheat and Faba Bean Plants. Microbiol. Res. 2000, 155, 221–227. [Google Scholar] [CrossRef]
- Salih, H.M.; Yahya, A.I.; Abdul-Rahem, A.M.; Munam, B.H. Availability of Phosphorus in a Calcareous Soil Treated with Rock Phosphate or Superphosphate as Affected by Phosphate-Dissolving Fungi. Plant Soil 1989, 120, 181–185. [Google Scholar] [CrossRef]
- Wang, J.; Zhao, Y.-G.; Maqbool, F. Capability of Penicillium oxalicum Y2 to Release Phosphate from Different Insoluble Phosphorus Sources and Soil. Folia Microbiol. (Praha) 2021, 66, 69–77. [Google Scholar] [CrossRef] [PubMed]
- Li, F.; Zhang, S.; Wang, Y.; Li, Y.; Li, P.; Chen, L.; Jie, X.; Hu, D.; Feng, B.; Yue, K.; et al. Rare Fungus, Mortierella capitata, Promotes Crop Growth by Stimulating Primary Metabolisms Related Genes and Reshaping Rhizosphere Bacterial Community. Soil Biol. Biochem. 2020, 151, 108017. [Google Scholar] [CrossRef]
- Tamayo-Velez, A.; Osorio, N.W. Co-Inoculation with an Arbuscular Mycorrhizal Fungus and a Phosphate-Solubilizing Fungus Promotes the Plant Growth and Phosphate Uptake of Avocado Plantlets in a Nursery. Botany 2017, 95, 539–545. [Google Scholar] [CrossRef]
- Cordell, D.; White, S. Tracking Phosphorus Security: Indicators of Phosphorus Vulnerability in the Global Food System. Food Secur. 2015, 7, 337–350. [Google Scholar] [CrossRef]
- Chowdhury, R.B.; Moore, G.A.; Weatherley, A.J.; Arora, M. Key Sustainability Challenges for the Global Phosphorus Resource, Their Implications for Global Food Security, and Options for Mitigation. J. Clean. Prod. 2017, 140, 945–963. [Google Scholar] [CrossRef]
- Condron, L.M.; Spears, B.M.; Haygarth, P.M.; Turner, B.L.; Richardson, A.E. Role of Legacy Phosphorus in Improving Global Phosphorus-Use Efficiency. Environ. Dev. 2013, 8, 147–148. [Google Scholar] [CrossRef]
- Zhu, J.; Li, M.; Whelan, M. Phosphorus Activators Contribute to Legacy Phosphorus Availability in Agricultural Soils: A Review. Sci. Total Environ. 2018, 612, 522–537. [Google Scholar] [CrossRef]
- Chittora, P.; Sharma, D.; Aseri, G.K.; Sohal, J.S.; Singh, D.; Khare, N.; Jain, N. Chapter 9—Fungi as Phosphate-Solubilizing Microorganisms in Arid Soil: Current Perspective. In New and Future Developments in Microbial Biotechnology and Bioengineering; Singh, J., Gehlot, P., Eds.; Elsevier: Amsterdam, The Netherlands, 2020; pp. 99–108. ISBN 978-0-12-821007-9. [Google Scholar]
- Bruulsema, T.W.; Peterson, H.M.; Prochnow, L.I. The Science of 4R Nutrient Stewardship for Phosphorus ManAgement across Latitudes. J. Environ. Qual. 2019, 48, 1295–1299. [Google Scholar] [CrossRef]
- Landínez-Torres, A.Y.; Becerra Abril, J.L.; Tosi, S.; Nicola, L. Soil Microfungi of the Colombian Natural Regions. Int. J. Environ. Res. Public. Health 2020, 17, E8311. [Google Scholar] [CrossRef]
- Hyde, K.D.; Xu, J.; Rapior, S.; Jeewon, R.; Lumyong, S.; Niego, A.G.T.; Abeywickrama, P.D.; Aluthmuhandiram, J.V.S.; Brahamanage, R.S.; Brooks, S.; et al. The Amazing Potential of Fungi: 50 Ways We Can Exploit Fungi Industrially. Fungal Div. 2019, 97, 1–136. [Google Scholar] [CrossRef]
- Vassileva, M.; Mocali, S.; Canfora, L.; Malusá, E.; García Del Moral, L.F.; Martos, V.; Flor-Peregrin, E.; Vassilev, N. Safety Level of Microorganism-Bearing Products Applied in Soil-Plant Systems. Front. Plant Sci. 2022, 13, 862875. [Google Scholar] [CrossRef] [PubMed]
- Madhavan, A.; Arun, K.; Sindhu, R.; Alphonsa Jose, A.; Pugazhendhi, A.; Binod, P.; Sirohi, R.; Reshmy, R.; Kumar Awasthi, M. Engineering Interventions in Industrial Filamentous Fungal Cell Factories for Biomass Valorization. Bioresour. Technol. 2022, 344, 126209. [Google Scholar] [CrossRef] [PubMed]
- Dörsam, S.; Fesseler, J.; Gorte, O.; Hahn, T.; Zibek, S.; Syldatk, C.; Ochsenreither, K. Sustainable Carbon Sources for Microbial Organic Acid Production with Filamentous Fungi. Biotechnol. Biofuels 2017, 10, 242. [Google Scholar] [CrossRef]
- Vassilev, N.; Eichler-Löbermann, B.; Vassileva, M. Stress-Tolerant P-Solubilizing Microorganisms. Appl. Microbiol. Biotechnol. 2012, 95, 851–859. [Google Scholar] [CrossRef]

Disclaimer/Publisher’s Note: The statements, opinions and data contained in all publications are solely those of the individual author(s) and contributor(s) and not of MDPI and/or the editor(s). MDPI and/or the editor(s) disclaim responsibility for any injury to people or property resulting from any ideas, methods, instructions or products referred to in the content. |
© 2023 by the authors. Licensee MDPI, Basel, Switzerland. This article is an open access article distributed under the terms and conditions of the Creative Commons Attribution (CC BY) license (https://creativecommons.org/licenses/by/4.0/).
Share and Cite
Vera-Morales, M.; López Medina, S.E.; Naranjo-Morán, J.; Quevedo, A.; Ratti, M.F. Nematophagous Fungi: A Review of Their Phosphorus Solubilization Potential. Microorganisms 2023, 11, 137. https://doi.org/10.3390/microorganisms11010137
Vera-Morales M, López Medina SE, Naranjo-Morán J, Quevedo A, Ratti MF. Nematophagous Fungi: A Review of Their Phosphorus Solubilization Potential. Microorganisms. 2023; 11(1):137. https://doi.org/10.3390/microorganisms11010137
Chicago/Turabian StyleVera-Morales, Marcos, Segundo E. López Medina, Jaime Naranjo-Morán, Adela Quevedo, and María F. Ratti. 2023. "Nematophagous Fungi: A Review of Their Phosphorus Solubilization Potential" Microorganisms 11, no. 1: 137. https://doi.org/10.3390/microorganisms11010137
APA StyleVera-Morales, M., López Medina, S. E., Naranjo-Morán, J., Quevedo, A., & Ratti, M. F. (2023). Nematophagous Fungi: A Review of Their Phosphorus Solubilization Potential. Microorganisms, 11(1), 137. https://doi.org/10.3390/microorganisms11010137

